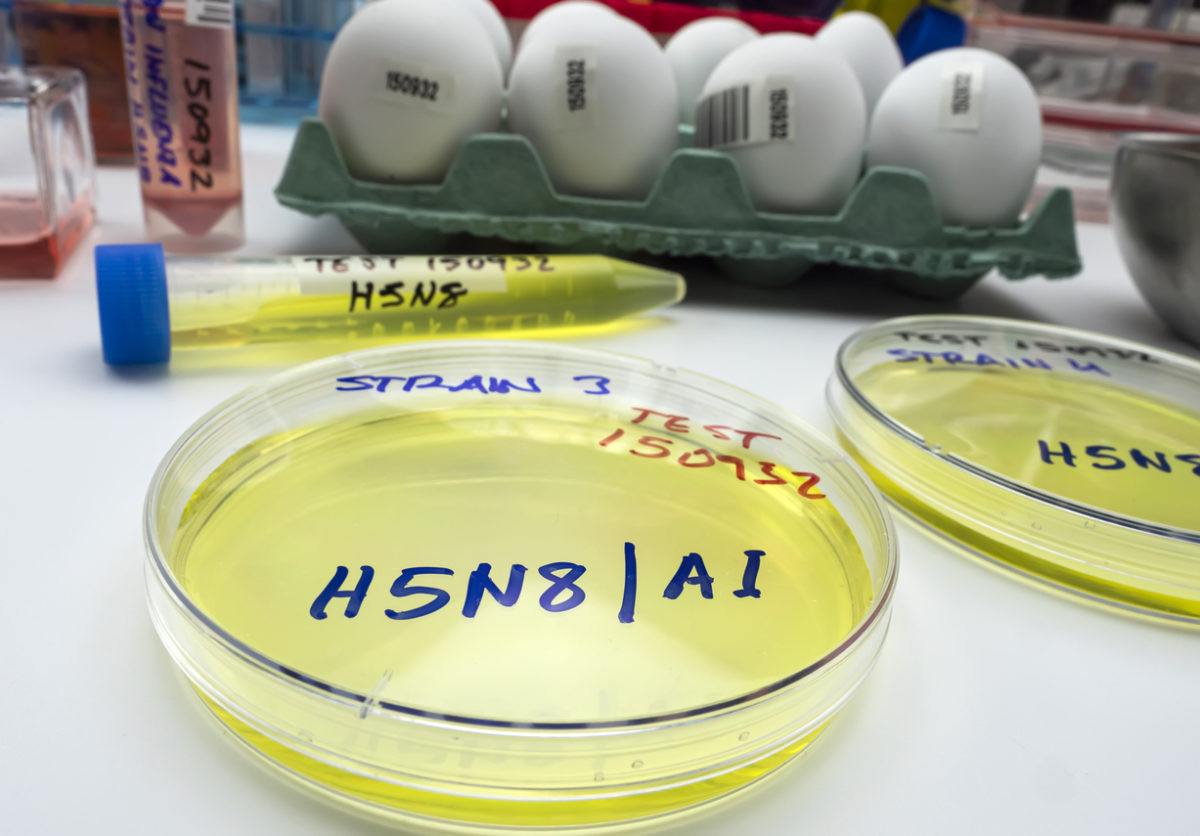

Η εμφάνιση και η παγκόσμια εξάπλωση του εξαιρετικά παθογόνου ιού της γρίπης των πτηνών H5N8 (avian influenza virus, ή AIV), που έχει προκαλέσει διαρκείς και συνεχιζόμενες επιδημίες με μαζική θνησιμότητα τόσο σε άγρια όσο και σε εκτρεφόμενα πτηνά σε ολόκληρη την Ευρασία και την Αφρική κατά τη διάρκεια του 2020, ανησυχεί τους ειδικούς.
Η γρίπη των πτηνών Η5Ν8 αντιπροσωπεύει ένα σημαντικό πρόβλημα για τη δημόσια υγεία, ιδιαίτερα αν λάβουμε υπόψη τα πρώτα ανθρώπινα κρούσματα που αναφέρθηκαν για πρώτη φορά τον περασμένο Δεκέμβριο του 2020.
Σε σχετικό άρθρο που δημοσίευσαν στο περιοδικό Science, οι Weifeng Shi και George Gao συζητούν την εμφάνιση και το ζωονοσογόνο (zoonotic) δυναμικό της οικογένειας H5 της γρίπης των πτηνών. Οι Shi και Gao υποστηρίζουν ότι η προσεκτική παρακολούθηση και τα αυστηρά μέτρα ελέγχου των λοιμώξεων γι’ αυτούς τους αναδυόμενους ιούς είναι ζωτικής σημασίας για να μην περάσουν στον άνθρωπο και οδηγήσουν σε νέες και καταστροφικές πανδημίες.
Η σοβαρή κατάσταση με την γρίπη των πτηνών Η5Ν8 έχει επισκιαστεί από τη συνεχιζόμενη πανδημία COVID-19.
Κατά το περασμένο έτος έχουν εντοπιστεί λοιμώξεις από H5N8 τόσο σε άγρια πτηνά όσο και σε πουλερικά σε τουλάχιστον 46 χώρες σε ολόκληρη την Ευρώπη, την Ασία και την Αφρική. Αν και αυτά τα κρούσματα έχουν οδηγήσει στο θάνατο ή τη σφαγή πολλών εκατομμυρίων πτηνών παγκοσμίως, έχουν επίσης οδηγήσει σε τουλάχιστον ένα περιστατικό μόλυνσης ανθρώπων στη Ρωσία, όπου επτά εργαζόμενοι σε κτηνοτροφικές μονάδες βρέθηκαν θετικοί στον ιό H5N8.
Εργαστηριακά τεστ σε δείγματα του ιού Η5Ν8 της γρίπης των πτηνών
Σύμφωνα με τους συγγραφείς, η ταχεία παγκόσμια εξάπλωση αυτού του τύπου γρίπης των πτηνών και η αποδεδειγμένη ικανότητά του να υπερπηδάει το φράγμα των ειδών και να μεταδίδεται στον άνθρωπο, το καθιστά μείζον ζήτημα όχι μόνο για την ασφάλεια της γεωργίας και της άγριας ζωής, αλλά και της παγκόσμιας δημόσιας υγείας.
Οι Shi και Gao προτείνουν ότι η επιτήρηση των εξαιρετικά παθογόνων ιών της γρίπης των πτηνών σε πτηνοτροφικές μονάδες, αγορές ζωντανών και άγριων πτηνών πρέπει να καταστεί παγκόσμια προτεραιότητα.
Πηγή: https://scitechdaily.com























